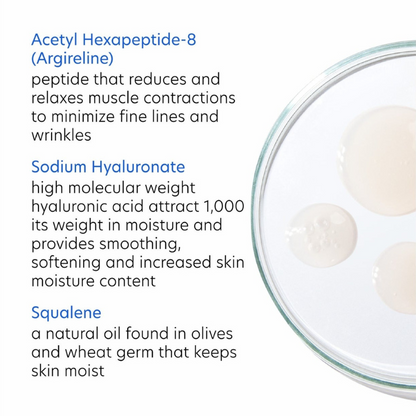
ExLinea® Peptide Smoothing Serum

SachiSkinStudio
ExLinea® Peptide Smoothing Serum
ExLinea® Peptide Smoothing Serum
Couldn't load pickup availability
- Fast & Secure Shipping
- 30-Day Return Policy
- Loved by Worldwide
Description
Description
This peptide spot treatment serum minimizes the appearance of expression lines and hydrates, smooths and firms aging skin.
- Minimizes the appearance of expression lines due to repeated facial muscle movements
- Firms, tightens and strengthens aging skin
- 1.0 fl oz/29.5 mL
Shipping Policy
Shipping Policy
At SachiSkinStudio, all orders are processed within 1 business day and delivered within 2–3 business days. Once shipped, you will receive a tracking number via email to monitor your order until it arrives.
Read more about the Shopping policy here.
Return Policy
Return Policy
We have a 30-day return policy, which means you have 30 days after receiving your item to request a return.
To be eligible for a return, your item must be in the same condition that you received it, unworn or unused, with tags, and in its original packaging. You’ll also need the receipt or proof of purchase.
Read more about the Return and refund policy here.
Share










"I choose products that heal, not conceal."
"Investing in my skin is investing in myself."
"My skin has the power to renew and restore"
"I release what no longer serves my skin"
"I choose products that heal, not conceal."
"Investing in my skin is investing in myself."
"My skin has the power to renew and restore"
"I release what no longer serves my skin"
SUBSCRIBE TO OUR EMAIL LIST
Be the first to know about skin VIP Promotions, client-only perks, and resultsdriven tips.